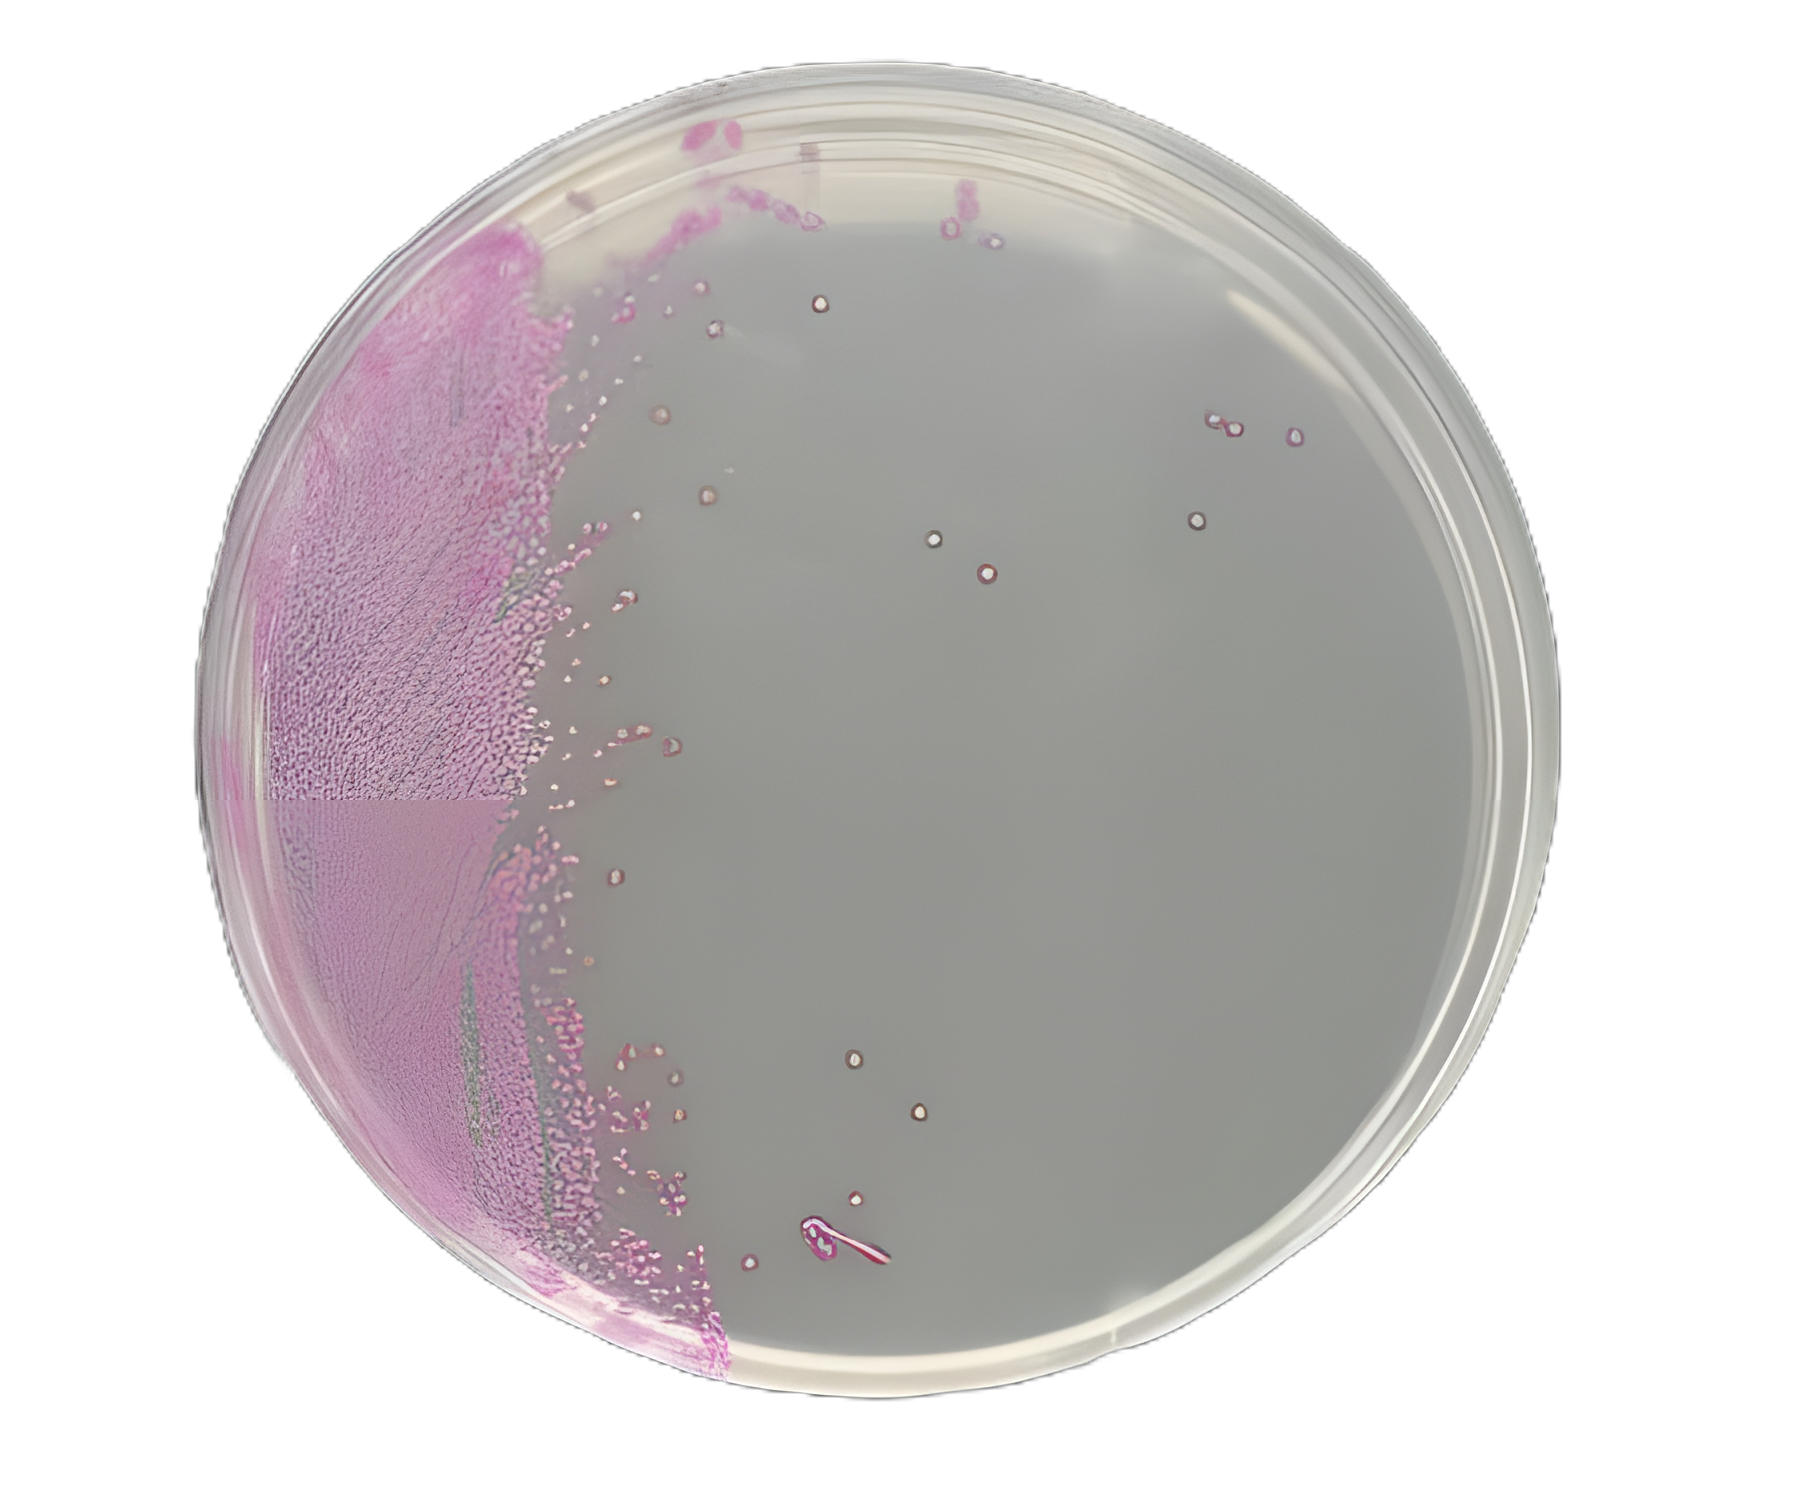
Culture Media HardyCHROM™ Staph Aureus Mono-plate Format

Compare
View Alternative
Culture Media HardyCHROM™ Staph Aureus Mono-plate Format
G311 | USAMP#33523021
volume
18 mL
dimensions
15 X 100 mm
Product Description
- HardyCHROM™ Staph aureus is a chromogenic medium recommended for the isolation, differentiation, and enumeration of Staphylococcus aureus by colony color
- S. aureus has also been implicated in nosocomial infections and food poisoning outbreaks
- HardyCHROM™ Staph aureus allows for the rapid and reliable detection of S. aureus from both clinical and food specimens within 24 hours
Product Specification
Manufacturer SKU
G311
Manufacturer
Hardy Diagnostics
Brand
HardyCHROM™
USAMP SKU
USAMP#33523021
Application
Culture Media
UNSPSC Code
41106212
Country Of Origin
Unknown
Storage Requirements
Requires Refrigeration
Volume
18 mL
Dimensions
15 X 100 mm
Type
Staph Aureus
Format
Mono-Plate Format
Cultivation Or Test Type
For the Isolation, Differentiation and Enumeration of Staphylococcus Aureus by Colony Color
Locked
Base Price
$45.65
BX
🎯 Unlock Your Custom Tiered Price
15-35% bulk discounts
100+
units
10% OFF
$XX.XX
per unit
Save $XXX
Payment Terms
Priority Shipping
Custom Contract Pricing
250+
units
20% OFF
$XX.XX
per unit
Save $XXX
Payment Terms
Priority Shipping
Custom Contract Pricing
500+
units
30% OFF
$XX.XX
per unit
Save $XXX
Payment Terms
Priority Shipping
Custom Contract Pricing
Unlock Bulk Pricing
See pricing for all volume tiers
Instant access to volume pricing. Register free to compare all tiers and calculate your exact savings.
5,000+ verified buyers
Average savings:$23,400/year
15-35% OFF
for healthcare facilities on bulk orders
24/7 Live Chat!
Instant support anytime